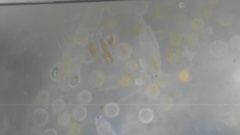
Peracarida

©Julia Carr, some rights reserved (CC-BY-NC)
©Julia Carr, some rights reserved (CC-BY-NC)
©tianran_hui, some rights reserved (CC-BY-NC)
©Karolle Wall, some rights reserved (CC-BY-NC)
©marcolopezlit, some rights reserved (CC-BY-NC)
©marcolopezlit, some rights reserved (CC-BY-NC)
©marcolopezlit, some rights reserved (CC-BY-NC)
©smellyturkey, some rights reserved (CC-BY-NC)
©smellyturkey, some rights reserved (CC-BY-NC)
©smellyturkey, some rights reserved (CC-BY-NC)
©smellyturkey, some rights reserved (CC-BY-NC)
©ksenia_emelyantseva, some rights reserved (CC-BY-NC)
©Norah Jane, some rights reserved (CC-BY-NC)
©Norah Jane, some rights reserved (CC-BY-NC)
©Norah Jane, some rights reserved (CC-BY-NC)
©Dennis Rabeling, some rights reserved (CC-BY-NC-ND)
©Dennis Rabeling, some rights reserved (CC-BY-NC-ND)
©Dennis Rabeling, some rights reserved (CC-BY-NC-ND)
©Dennis Rabeling, some rights reserved (CC-BY-NC-ND)
©Dennis Rabeling, some rights reserved (CC-BY-NC-ND)
©Tiffany Theden, some rights reserved (CC-BY-NC)
©Tiffany Theden, some rights reserved (CC-BY-NC)
©Tiffany Theden, some rights reserved (CC-BY-NC)
©Tiffany Theden, some rights reserved (CC-BY-NC)
©Paul Sorensen, some rights reserved (CC-BY-NC)
©Paul Sorensen, some rights reserved (CC-BY-NC)
©Paul Sorensen, some rights reserved (CC-BY-NC)
©Sylvain Le Bris, some rights reserved (CC-BY-NC)
©Luis Ferreira, some rights reserved (CC0)
©Luis Ferreira, some rights reserved (CC0)
©Luis Ferreira, some rights reserved (CC0)
©Luis Ferreira, some rights reserved (CC0)
©Guelph Lake Nature Centre, some rights reserved (CC-BY-NC)
©Harrison J Elkins, some rights reserved (CC-BY)
©Harrison J Elkins, some rights reserved (CC-BY)
©Harrison J Elkins, some rights reserved (CC-BY)
©azymela, some rights reserved (CC-BY-NC)
©Nick Shaw, some rights reserved (CC-BY-NC)
©kelptaylor, some rights reserved (CC-BY-NC)
©hollowdayemily, some rights reserved (CC-BY-NC)
©Katie Kucera, some rights reserved (CC-BY)
©Katie Kucera, some rights reserved (CC-BY)
©Tahic Kolas, some rights reserved (CC-BY-NC)
©Tahic Kolas, some rights reserved (CC-BY-NC)
©Tahic Kolas, some rights reserved (CC-BY-NC)
©Tahic Kolas, some rights reserved (CC-BY-NC)
©christrent, some rights reserved (CC-BY-NC)
©narasm, some rights reserved (CC-BY-NC)
©Benny Albro, some rights reserved (CC-BY-NC)
©Benny Albro, some rights reserved (CC-BY-NC)
©Benny Albro, some rights reserved (CC-BY-NC)
©Benny Albro, some rights reserved (CC-BY-NC)
©Benny Albro, some rights reserved (CC-BY-NC)
©cf125, some rights reserved (CC-BY)
©sarosaurus, some rights reserved (CC-BY-NC)
©sarosaurus, some rights reserved (CC-BY-NC)
©tinaturtlestoday, some rights reserved (CC-BY-NC)
©Fabian EGL, some rights reserved (CC-BY-NC)
©Fabian EGL, some rights reserved (CC-BY-NC)
©Fabian EGL, some rights reserved (CC-BY-NC)
©Lucy London, some rights reserved (CC-BY-NC)
©Lucy London, some rights reserved (CC-BY-NC)
©Lucy London, some rights reserved (CC-BY-NC)
©nfwalters, some rights reserved (CC-BY-NC)
©emmaarmstrong__, some rights reserved (CC-BY-NC)
©Tabaré Barreto, some rights reserved (CC0)
©Fernando Sessegolo, some rights reserved (CC0)
©David CP, some rights reserved (CC-BY-NC)
©David CP, some rights reserved (CC-BY-NC)
©gerls, some rights reserved (CC-BY-NC)
©Jenny Saito, some rights reserved (CC-BY-NC)
©Jenny Saito, some rights reserved (CC-BY-NC)
©emilio_bio, some rights reserved (CC-BY-NC)
©niyasaige, some rights reserved (CC-BY-NC)
©Tomáš Hovorka, some rights reserved (CC-BY-NC)
©kelptaylor, some rights reserved (CC-BY-NC)
©Theo Summer, some rights reserved (CC-BY)
©Theo Summer, some rights reserved (CC-BY)
©Theo Summer, some rights reserved (CC-BY)
©Theo Summer, some rights reserved (CC-BY)
©Gavin Johnstone, some rights reserved (CC-BY-NC)
©gavinbw, some rights reserved (CC-BY-NC)
©Tim, some rights reserved (CC-BY)
©Tim, some rights reserved (CC-BY)
©Tim, some rights reserved (CC-BY)
©Tim, some rights reserved (CC-BY)
©Tim, some rights reserved (CC-BY)
©shingha4223, some rights reserved (CC-BY-NC)
©james-patrick, some rights reserved (CC-BY-NC)
©irenebeanthesciencemachine, some rights reserved (CC-BY-NC)
©Lucila Boasso, some rights reserved (CC-BY-NC)
©Lucila Boasso, some rights reserved (CC-BY-NC)
©catchwords, some rights reserved (CC-BY)
©gmcqueen, some rights reserved (CC-BY-NC)
©hsug1747, some rights reserved (CC-BY-NC)
©hsug1747, some rights reserved (CC-BY-NC)
©hsug1747, some rights reserved (CC-BY-NC)
©hernandez_gabriela, some rights reserved (CC-BY-NC)
©fungi-hunter, some rights reserved (CC-BY-NC)
©fungi-hunter, some rights reserved (CC-BY-NC)
©Ainsley, some rights reserved (CC-BY-NC)
©Ainsley, some rights reserved (CC-BY-NC)
©Corey Farwell, some rights reserved (CC-BY)
©Khadija El bouchikhi, some rights reserved (CC-BY-NC)
©Khadija El bouchikhi, some rights reserved (CC-BY-NC)
©Luke Foster, some rights reserved (CC-BY-NC)
©Luke Foster, some rights reserved (CC-BY-NC)
©Dinesh Sharma, some rights reserved (CC-BY-NC)
©Dinesh Sharma, some rights reserved (CC-BY-NC)
©Dinesh Sharma, some rights reserved (CC-BY-NC)
©Dinesh Sharma, some rights reserved (CC-BY-NC)
©cassieferri, some rights reserved (CC-BY-NC)
©Justin, some rights reserved (CC-BY-NC)
©Justin, some rights reserved (CC-BY-NC)
©Justin, some rights reserved (CC-BY-NC)
©Justin, some rights reserved (CC-BY-NC)
©Scott Loarie, some rights reserved (CC0)
©Adrian Cotter, some rights reserved (CC-BY-NC-SA)
©Adrian Cotter, some rights reserved (CC-BY-NC-SA)
©kaz, some rights reserved (CC-BY-NC)
©Donna Pomeroy, some rights reserved (CC-BY-NC)
©Donna Pomeroy, some rights reserved (CC-BY-NC)
©Liam O'Brien, some rights reserved (CC-BY-NC)
©Liam O'Brien, some rights reserved (CC-BY-NC)
©Liam O'Brien, some rights reserved (CC-BY-NC)
©Donna Pomeroy, some rights reserved (CC-BY-NC)
©jthomas19, some rights reserved (CC-BY-NC)
©Damon Tighe, some rights reserved (CC-BY-NC)
©sarahnwilson, some rights reserved (CC-BY-NC)
©Cathleen, some rights reserved (CC-BY-NC)
©Kate McCombs, some rights reserved (CC-BY-NC)
©Kate McCombs, some rights reserved (CC-BY-NC)
©Kate McCombs, some rights reserved (CC-BY-NC)
©Kate McCombs, some rights reserved (CC-BY-NC)
©ikernf, some rights reserved (CC0)
©tonyroberts, some rights reserved (CC-BY-NC)
©letravaildevie, some rights reserved (CC-BY-NC)
©Josie Lopez, some rights reserved (CC-BY-NC)
©Annette Mercer, some rights reserved (CC-BY-NC)
©Shawna Stambaugh, some rights reserved (CC-BY-NC)
©Alison Young, some rights reserved (CC-BY-NC)
©Kelly Fuerstenberg, some rights reserved (CC-BY-NC)
©Thomas Barbin, some rights reserved (CC-BY-NC)
©Thomas Barbin, some rights reserved (CC-BY-NC)
©Thomas Barbin, some rights reserved (CC-BY-NC)
©Thomas Barbin, some rights reserved (CC-BY-NC)
©Thomas Barbin, some rights reserved (CC-BY-NC)
©Thomas Barbin, some rights reserved (CC-BY-NC)
©zorthor, some rights reserved (CC-BY-NC)
©Julie, some rights reserved (CC-BY-NC)
©Julie, some rights reserved (CC-BY-NC)
©Julie, some rights reserved (CC-BY-NC)
©mncrowley, some rights reserved (CC-BY-NC)
©mncrowley, some rights reserved (CC-BY-NC)
©whodamanhd, some rights reserved (CC-BY-NC)
©dlbowls, some rights reserved (CC-BY-NC)
©dlbowls, some rights reserved (CC-BY-NC)
©dlbowls, some rights reserved (CC-BY-NC)
©Rebecca Lloyd, some rights reserved (CC-BY-NC)
©Rebecca Lloyd, some rights reserved (CC-BY-NC)